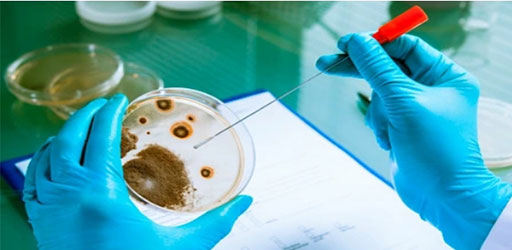
Hefe-Zwei-Hybrid-Screening

Über 10 Jahre Erfahrung in Hefe-Hybrid-Systemen
Ver öffentlichte Kooperationen in Wissenschaft, Natur und mehr
12-stufige Qualitäts kontrolle im gesamten Workflow
Gebrauchs fertige Bibliotheks vektoren und Hefe stämme enthalten
End-to-End-Projekt beratung und schnelle technische Unterstützung
Von der Proben vorbereitung bis hin zu bio informatik ischen Erkenntnissen
Sind Sie bereit, das Hefe-Hybrid-Screening zu erkunden?
Erzählen Sie uns von Ihrem Muster typ oder Ihren Forschungs zielen-unser Team empfiehlt den am besten geeigneten Bibliotheks bau-und Screening-Service.
Senden Sie Ihre Muster nach unseren klaren Richtlinien.
Mit Labors in ganz Europa, den USA und Asien unterstützen wir die internat ionale Bereitstellung und bieten Unterstützung bei der Vorbereitung von Nuklear-, Membran-oder Expressions bibliotheken.
Erhalten Sie QC-verifizierte Screening-Daten sowie positive Klone, Vektoren und Follow-up-Unterstützung, um Ihre Forschung voran zutreiben.
Mit Labor betrieben in den USA, Europa und Asien bieten wir reaktions schnelle Unterstützung für internat ionale Projekte und Studien mit mehreren Standort bereichen. Eine abgestimmte Logistik sorgt für pünktliche Lieferung und Musters tabilität-egal wo Ihre Recherche stattfindet.

Singapur Globaler Hauptsitz:112 ROBINSON ROAD #03-01
Germany: Arnold-Graffi-Haus / D85 Robert-Rössle-Straße 10 13125 Berlin
Vereinigte Staaten:2 Goddard, Irvine, CA 92618, Vereinigte Staaten
Hong Kong:Wohnung 1019B, 10/F, Liven House, Nr. 61-63 King Yip Street, Kwun Tong
Singapur Globaler Hauptsitz:112 ROBINSON ROAD #03-01
Germany: Arnold-Graffi-Haus / D85 Robert-Rössle-Straße 10 13125 Berlin
Vereinigte Staaten:2 Goddard, Irvine, CA 92618, Vereinigte Staaten
Hong Kong:Wohnung 1019B, 10/F, Liven House, Nr. 61-63 King Yip Street, Kwun Tong